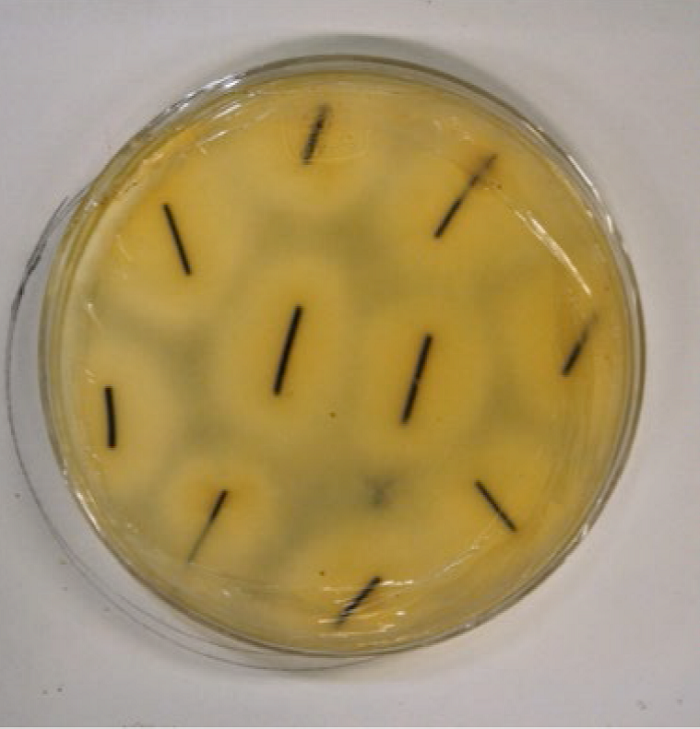

Artículos científicos
Recepción: 10 Marzo 2022
Aprobación: 03 Julio 2023
Publicación: 20 Diciembre 2023
DOI: https://doi.org/10.21829/myb.2023.2932472
Resumen: En México, los hongos ectomicorrizógenos silvestres (HEcM) son un importante recurso forestal no maderable y son aprovechados tradicionalmente para su autoconsumo y venta. La conservación in vitro de cepas de HEcM es más compleja que en especies saprófitas, debido a las relaciones fisiológicas existentes con sus hospederos. En este trabajo se presenta un método de crioconservación de cepas de HEcM utilizando vectores no convencionales y la posterior evaluación de su viabilidad in vitro. Para ello, cinco cepas de HEcM (Boletus aff. edulis, Boletus sp., Helvella sp. y Lactarius indigo [2]) fueron criogenizadas (-196 °C) durante 30 días, utilizando como vectores acículas de pino y semillas de mijo estériles. Posteriormente, se determinó la capacidad de dos de las cepas recuperadas para formar morfotipos de ectomicorrizas in vitro inoculados en plántulas de Pinus montezumae. Los resultados de la primera etapa mostraron altos porcentajes de recuperación de los micelios criogenizados en ambos vectores (98% - 100%). En cuanto a la micorrización in vitro, las plántulas no micorrizadas (control) no sobrevivieron, mientras que las micorrizadas mostraron valores de sobrevivencia entre 33% y 100%, con incremento de la longitud de sus tallos. Además, se observó la formación de morfotipos dicotómicos de color ocre oscuro, así como el desarrollo del manto fúngico en las raíces micorrizadas después de cuatro meses de inoculación. El método empleado para la criogenización de las cepas de HEcM posibilita la conservación de los micelios por períodos prolongados, manteniendo activa su capacidad de micorrización.
Palabras clave: Boletus edulis, Helvella sp., hongos comestibles, México, micorrización in vitro, nitrógeno líquido.
Abstract: In Mexico, wild ectomycorrhizal fungi (EcMF) are an important non-timber forest resource and are part of the traditional harvesting for selfconsumption and sale. The in vitro maintenance of EcMF strains is more complex than in saprophytic species due to the physiological relationships with their hosts. This paper presents a cryopreservation method of EcMF strains using unconventional vectors and the subsequent evaluation of their viability in vitro. To this end, five ECMF strains (Boletus aff. edulis, Boletus sp., Helvella sp., and Lactarius indigo [2]) were cryopreserved (-196 °C) for 30 days, using sterile pine needles and millet seeds as vectors. Subsequently, the ability of two of the recovered strains to form ectomycorrhizal morphotypes in vitro inoculated in Pinus montezumae seedlings was determined. The results of the first stage showed high percentages of recovery of cryogenic mycelia in both vectors (98% - 100%). Regarding in vitro mycorrhization, non-mycorrhizal seedlings (control) did not survive, while mycorrhizal seedlings showed survival values between 33% and 100% and increases in the length of their stems. In addition, the formation of dichotomous morphotypes of dark ochre color was observed, as well as the development of the fungal mantle in the mycorrhizal roots after four months of inoculation. The method used for the cryogenization of EcMF strains allows the conservation of mycelia for prolonged periods, maintaining their mycorrhization capacity active.
Keywords: Boletus edulis, Helvella sp., edible mushrooms, Mexico, in vitro mycorrhization, liquid nitrogen.
Introducción
En México, los hongos comestibles silvestres son un importante recurso forestal no maderable, con más de 450 especies recolectadas para autoconsumo y venta en los mercados locales, por lo que este país es considerado uno de los principales reservorios culturales y biológicos a escala mundial (Pérez-Moreno et al., 2021). Entre las especies comestibles recolectadas destacan los hongos ectomicorrizógenos (HEcM), algunos de ellos con altos valores culinarios y asociados a árboles de importancia forestal (Burrola-Aguilar et al., 2012; Garibay-Orijel et al., 2013; Garibay-Orijel y Ruan-Soto, 2014; Baeza-Guzmán et al., 2017), ya que México posee 40% de los géneros conocidos del mundo (Pérez-Moreno et al., 2019) y ocupa el 9º lugar en vegetación arbórea endémica (Organización de las Naciones Unidas para la Alimentación y la Agricultura [FAO, por sus siglas en ingles], 2020). En contraste, esta región presenta una alta tasa de deforestación, ya que tan solo en el periodo de 1990-2005, se calculó una pérdida anual de 318 000 ha de bosque (Pérez-Moreno et al., 2020).
Frente a las altas tasas de deforestación registradas para las regiones boscosas en México, se requiere, entre otros factores, una mejor comprensión de la estructura y el funcionamiento de la simbiosis ectomicorrícica y un mejor rendimiento de la micorrización artificial de plántulas inoculadas en condiciones de vivero y campo (Pérez-Moreno et al., 2021), especialmente por los beneficios que esta asociación simbiótica ofrece para la recuperación del bosque (Camargo-Ricalde et al., 2012; Ramírez Miguel et al., 2021).
Hasta ahora, los avances biotecnológicos permiten la inoculación de semillas y plántulas de árboles hospederos con algunas especies de HEcM, (Repác, 2011; Martínez-Reyes et al., 2012; Endo et al., 2014; Pérez-Moreno et al., 2020). Estas técnicas incrementan la supervivencia en condiciones difíciles para la planta, como las que enfrenta al ser trasplantadas de vivero a campo, favoreciendo la absorción de agua y nutrientes y aumentando la resistencia a patógenos (Carrasco-Hernández et al., 2011; Arteaga-León et al., 2018). Además, se han desarrollado inoculantes comerciales con esporas y cultivos miceliales, principalmente de los géneros Pisolithus, Scleroderma y Rhizopogon (Gasteromicetos no comestibles), Laccaria y Suillus (especies de Agaricales comestibles) dispuestos para su aplicación en semillas o plantas de importancia forestal, tanto en regiones tropicales como templadas (Brundrett et al., 1996; Chávez et al. 2009; Islam y Ohga, 2013; Zong et al., 2015).
Las técnicas que emplean cultivos miceliales de HEcM requieren de procesos previos de aislamiento y selección de cepas con la finalidad de identificar el germoplasma más adecuado para su propagación y reproducción, así como de métodos de preservación in vitro que permitan mantener estables las características morfológicas, genéticas y fisiológicas de los cultivos (Crahay, Declerck, et al., 2013; Hernández-Santiago et al., 2021).
De acuerdo con Hawksworth (2004), solo se ha conservado in vitro 1.3% de la biodiversidad fúngica global de 1.5 millones de especies, especialmente especies saprobias. En el caso de especies micorrizógenas, aunque las condiciones estériles de laboratorio están lejos de las naturales, las técnicas de síntesis de cultivos puros son necesarias para estudios de compatibilidad, estructurales, fisiológicos y moleculares, entre otros (Pérez-Moreno et al., 2021).
A través de los años se han probado distintos métodos para mantener estable el germoplasma de los hongos en el laboratorio (Homolka, 2013), siendo la liofilización y la criogenización dos técnicas que han ganado terreno y preferencia, sobre todo para el estudio de hongos filamentosos que, tras la reducción metabólica y maximización de la estabilidad genética, posibilitan su almacenamiento y estudio posterior (Crahay, Declerck, et al. 2013; Lalaymia et al., 2014; Linde et al., 2018). La congelación de micelios de especies de hongos utilizando semillas de gramíneas como vectores (Mata y Pérez Merlo, 2003) ha resultado exitosa en especies saprófitas, pero aún no había sido probada con HEcM. Se sabe, sin embargo, que los HEcM pueden sobrevivir utilizando diferentes protocolos de congelación, a temperaturas ultrabajas en contenedores de nitrógeno (Obase et al., 2011; Crahay et al., 2017). Con los protocolos de congelación de los HEcM es importante considerar que, además de mantener la estabilidad de las características genéticas, fenotípicas y fisiológicas de las cepas, es vital no afectar su capacidad para formar asociaciones micorrícicas después de la congelación (Crahay, Wevers, et al., 2013). Por lo anterior, en el presente estudio se evaluó la capacidad de sobrevivencia de distintas cepas de HEcM sometidas a congelación y su posterior recuperación con la finalidad de determinar si el tratamiento de criogenización afectaba su capacidad para formar asociaciones simbióticas in vitro con plántulas de pinos.
Objetivos
Los objetivos del presente estudio fueron i) evaluar la recuperación micelial de cepas de HEcM criogenizadas, utilizando como vectores semillas de mijo y acículas de pino estériles, y ii) determinar la capacidad in vitro de los micelios HEcM recuperados para desarrollar morfotipos asociados a la formación de micorrizas en plántulas de Pinus montezumae, como un proceso viable de conservación de germoplasma de especies ectomicorrizógenas.
Materiales y métodos
Criogenización de las cepas
Cepas estudiadas y preparación de los vectores
Se estudiaron cinco cepas de HEcM: Boletus aff. edulis (IE1305) Boletus sp. (IE-1316), Helvella sp. (IE-1317) y Lactarius indigo (IE-1318, IE-1319). Las cepas fueron aisladas de los especímenes Medel-Mata 2016, Córdova 25, Medel 2072, Camacho 659 y Camacho 674, respectivamente. Todos los ejemplares fueron recolectados en la zona del Parque Nacional del Cofre de Perote, ubicado en la parte central del estado de Veracruz (México) y se encuentran depositados en la Colección Micológica “Gastón Guzmán” del Herbario XAL del Instituto de Ecología, A.C., en Xalapa (México). La identificación de los ejemplares se llevó a cabo de acuerdo con los criterios de Mata (1999), Mata et al. (2003) y Miller y Miller (2006), siguiendo las técnicas rutinarias en micología (Largent et al., 1977), lo cual consiste en hacer preparaciones temporales montadas en KOH 5%, azul de algodón en lactofenol, floxina y rojo Congo.
Las cepas fueron registradas y depositadas para su conservación en el cepario de hongos del Instituto de Ecología, A.C. Para su criogenización, las cepas de HEcM se precultivaron a 21 °C ± 1 °C durante 30 días en cajas de Petri con medio de cultivo de agar con papa y dextrosa (PDA, Bioxon) y después se colocaron en los vectores para su congelación (Mata y Salmones, 2005).
Los vectores utilizados para la congelación de las cepas fueron semillas de mijo (Panicum miliaceum L.) y acículas de pino, estas últimas colectadas en la región boscosa donde se colectaron los especímenes de hongos. Las acículas se cortaron en fragmentos de 1 cm de largo. Ambos vectores se lavaron con agua corriente y se mantuvieron en remojo, por separado, durante 12 h. Posteriormente, se colocaron en agua caliente (65 °C) durante 15 min para favorecer su reblandecimiento y se escurrieron para drenar el exceso de humedad. A las semillas de mijo se les adicionó 0.5% (peso seco) de una mezcla 1:1 de CaCO3 y CaSO4 además de 2.5% de turba. Los vectores se colocaron en bolsas de polipropileno y se esterilizaron en autoclave a 121 °C durante 90 min. Después de enfriarse, se colocaron 15 g de cada sustrato en cajas de Petri estériles de 60 mm de diámetro, que se inocularon con un disco de micelio (± 0.5 cm de diámetro) de cada cepa precultivada en PDA. Las muestras se incubaron en condiciones de oscuridad a 21 °C ± 1 ºC para permitir que el micelio cubriera a los vectores estériles contenidos en las cajas de Petri, aproximadamente 15 días a 30 días de incubación.
Congelación y descongelación de las cepas
Para la congelación de las cepas se utilizaron viales de policarbonato (Nalgene) de 2 mL de capacidad. En cada vial se agregaron 1.5 mL de una solución crioprotectora de glicerol a 10% (v/v), tanto los viales como el glicerol fueron esterilizados a 121 °C durante 60 min. En las muestras estériles se colocaron 10 semillas de mijo o acículas de pino completamente cubiertas de micelio. Se prepararon cinco viales por cada vector y cepa. Las muestras permanecieron 1 h en contacto con la solución crioprotectora a temperatura ambiente (25 °C) y posteriormente se introdujeron en el contenedor de nitrógeno líquido (-196 °C).
Las muestras permanecieron congeladas durante 30 días. Transcurrido este periodo, los viales se retiraron del contenedor de nitrógeno líquido y se descongelaron introduciéndolos en un baño maría preparado con agua destilada estéril a 30 °C, durante 10 min (Mata y Pérez Merlo, 2003). Una vez descongelados, los viales se desinfectaron durante 1 min en una solución de etanol al 70% (v/v), retirando el exceso de la solución protectora de glicerol y transfiriendo los vectores con micelio a cajas de Petri estériles.
Viabilidad de las cepas
Para evaluar el efecto de la congelación sobre la recuperación y crecimiento de los micelios, se colocaron 10 semillas o acículas de pino con micelio descongeladas en cajas de Petri con PDA, preparando cinco réplicas para cada condición, en total de 50 réplicas por cada vector. Las muestras se incubaron a 21 °C ± 1 °C. Se determinó el porcentaje de muestras recuperadas a través de observaciones semanales. Una muestra se consideró recuperada cuando se observó al microscopio estereoscópico crecimiento micelial en los vectores. Además, se determinó el crecimiento micelial de las cepas criogenizadas y sus testigos no criogenizados, siguiendo la metodología de Mata y Pérez Merlo (2003). Para ello, se inoculó un vector con micelio en la parte central de una caja de Petri con PDA, en condiciones de esterilidad. Se prepararon ocho muestras de cada vector y cepa, y se incubaron a 21 °C ± 1 °C en oscuridad durante 20 días. Al final de la incubación, se tomaron fotografías de cada caja de Petri y se obtuvo el área de crecimiento micelial (cm2) utilizando el programa ImageJ (Rasband, 2009). La corroboración de la identidad de los micelios recuperados se basó en observaciones macro y microscópicas de los cultivos, de acuerdo con las descripciones realizadas por López Santiago (2013) descartando las muestras que presentaran alguna contaminación bacteriana y/o fúngica (mohos).
Cultivo y micorrización de las plántulas
Se utilizaron semillas de P. montezumae Lamb. donadas por la gerencia estatal de Veracruz de la Comisión Nacional Forestal (Conafor) y que procedían de la misma región montañosa donde se colectaron los hongos. Las dos cepas que presentaron mayor variabilidad de crecimiento entre las muestras control y las sometidas a congelamiento en acículas de pino (IE-1305, Boletus aff. edulis) y semillas de mijo (IE-1317, Helvella sp.), fueron seleccionadas para evaluar su capacidad de micorrización in vitro.
Desinfección y germinación de las semillas
Se prepararon dos lotes de entre 450 y 470 semillas de P. montezumae que fueron tratadas siguiendo la metodología de Gómez Viveros (2013) y Pérez Ochoa (2014). Para ello, inicialmente fueron sumergidas en una solución de detergente comercial a 10% de concentración y mantenidas en agitación durante 15 min, para posteriormente retirar la solución jabonosa mediante enjuagues en agua potable. La desinfección de uno de los lotes, tratamiento 1 (T1), consistió en sumergir las semillas sucesivamente en las siguientes soluciones: peróxido de hidrógeno (H2O2) a 3% de concentración durante 15 min, etanol a 70% durante 2 min e hipoclorito de sodio (6%) adicionando con 0.25% de Tween 20, manteniéndose esta última solución en agitación durante 30 min. Posteriormente y bajo condiciones asépticas, se realizaron tres enjuagues de 5 min cada uno con agua potable esterilizada (121 °C, 15 min); mientras que las semillas del segundo lote, definido como tratamiento 2 (T2), solo se sumergieron durante 2 min en una solución de etanol a 70%. En ambos tratamientos y al concluir el tercer enjuague en agua estéril, las semillas se dejaron hidratar durante 24 h, en oscuridad. Después del periodo de hidratación, se realizó la escarificación de las semillas. A la mitad de las muestras provenientes de ambos lotes se les aplicó escarificación completa (EC) que consistió en retirar, con ayuda de unas pinzas y bisturí, las dos cubiertas cutinizadas de las semillas para dejar expuesto el gametofito; mientras que al resto de muestras se les aplicó una escarificación incompleta (EI) que consistió en solo exponer la testa de la semilla, sin retirar las cubiertas. En ambos casos, los gametofitos fueron conservados en cajas de Petri estériles con agua estéril, para evitar su deshidratación, hasta la siembra en los sustratos.
Para la siembra de las semillas de P. montezumae se utilizaron dos sustratos: medio Woody Plant Medium (WPM), enriquecido con 30 g·L-1 de sacarosa, 0.5 g·L-1 de carbón activado y 6 g·L-1 de agar, ajustado a un pH de 5.5 ± 0.1 y el segundo sustrato (S) consistió en una mezcla de tierra negra, lombricomposta y tepetzil en proporción 1:1:1 (v/v). En frascos de vidrio de 110 mL de capacidad se colocaron 20 mL del medio WPM o 20 g de la mezcla S con 10 mL a15 mL de agua destilada estéril. Los frascos fueron tapados con papel aluminio y esterilizados en autoclave a 121 °C durante 90 min (Gómez Viveros, 2013). La siembra consistió en colocar 5 semillas en cada muestra, preparando 10 réplicas por tipo de sustrato. Las semillas se incubaron a 21 °C ± 1 °C, con fotoperiodos de 12 h de (luz del día) por medio de dos lámparas de 75W.
Producción de micelio en cultivo líquido
Los micelios de las cepas de Boletus edulis IE-1305 y Helvella sp. IE-1317 criogenizadas y no criogenizadas (micelios control) fueron inoculados en matraces Erlenmeyer conteniendo 150 mL de medio líquido Melin Norkrans modificado (MNM) (Marx, 1969) previamente esterilizados a 121 °C durante 20 min. La inoculación consistió en colocar cinco fragmentos de micelios (0.5 cm de diámetro) en cada uno de los matraces. Las muestras se incubaron a 25 °C, en agitación constante a 50 revoluciones por minuto, durante cuatro semanas.
Inoculación in vitro de las plántulas
Se eligieron 32 plántulas de P. montezumae provenientes de la combinación de tratamientos que alcanzó el mayor porcentaje de germinación (T1/ EC/S) y que presentaban un tamaño similar de tallo, hojas verdaderas y raíces secundarias definidas, para inocular los micelios de las cepas criogenizadas (C) y no criogenizadas (NC) cultivadas en acículas de pinos. Adicionalmente se hicieron muestras con plántulas sin micelio (testigo). El proceso consistió en extraer las plántulas del sustrato, enjuagarlas con agua destilada estéril, teniendo la precaución de eliminar restos de materiales extraños sin lastimar las raíces secundarias y posteriormente inocularlas con fragmentos de los micelios cultivados en el medio liquido MNM.
En condiciones de esterilidad, los micelios se filtraron del medio líquido, fragmentándolos en tamaño similar al del sistema radicular de las plántulas, para que lo cubriera por completo. Para realizar la inoculación in vitro, se utilizaron piezas cilíndricas del material conocido como espuma agrícola hidropónica o “peat foam”. Dichas piezas, de 4 cm de altura por 2 cm de diámetro, se obtuvieron con ayuda de un sacabocados metálico. Obtenidos los cilindros principales, con otro sacabocados más pequeño de 5 mm de diámetro, se extrajeron alrededor de 3 cm de altura de peat foam de la parte central del cilindro, para facilitar el acomodo del sistema radicular de la plántula y favorecer que el fragmento de micelio quedase completamente en contacto con la raíz.
Una vez inoculadas las plántulas, los cilindros se colocaron en tubos de ensaye de vidrio estériles, agregándoles 20 mL de medio de cultivo MNM (Fig. 1). Los tubos se incubaron durante cuatro meses a una temperatura de 21 °C ± 1 °C, con un fotoperiodo de 16 h y una intensidad luminosa de 50 lux (luz del día) proporcionada por dos lámparas de 75W. Las variables medidas en esta etapa fueron: 1) porcentaje de supervivencia de las plántulas, 2) diferencia de la altura del tallo entre el día de inoculación y la terminación del experimento, y 3) formación de estructuras que evidenciaran la presencia de micorriza mediante la observación al microscopio de las raíces de las plántulas inoculadas con las cepas.

Análisis estadístico
Tanto los datos de crecimiento micelial de las muestras criogenizadas como los datos de altura de las plántulas fueron examinados mediante un análisis de varianza bifactorial y una prueba de rangos múltiples de Tukey (α=0.05) para determinar las diferencias significativas entre las medias, mediante el paquete estadístico STATISTICA 8 (StatSoft, 2008).
Resultados
Viabilidad de las cepas criogenizadas
El porcentaje de viabilidad de las cepas criogenizadas fluctuó entre 98% y 100%, mientras que en las cepas sin criogenizar se mantuvo en 100 % (Tabla 1). A los 21 días de incubación, se observaron diferentes patrones de crecimiento micelial en las cepas. Los cultivos de Boletus aff. edulis (IE-1305) y Helvella sp. (IE-1317) presentaron un menor crecimiento micelial en las muestras recuperadas de la congelación, siendo estadísticamente significativa la diferencia entre los resultados alcanzados en acículas (IE1317) y mijo (IE-1305). Por el contrario, la cepa de Lactarius indigo (IE-1318) mostró un crecimiento mayor en las muestras congeladas, especialmente en el vector mijo. Por su parte, las cepas de Boletus sp. (IE-1316) y Lactarius indigo (IE-1319) presentaron un crecimiento micelial similar en todas las condiciones estudiadas; aunque los menores diámetros miceliales se desarrollaron en la cepa IE-1319 (Fig. 2).


En relación con el vector utilizado, en todas las condiciones experimentadas se observó desarrollo micelial de las cinco cepas, aunque hubo variaciones de respuesta (Fig. 3). En promedio, los diámetros miceliales mayores correspondieron a las muestras cultivadas en mijo, aunque estadísticamente solo se lograron detectar diferencias significativas para los micelios criogenizados de Boletus aff edulis IE-1305. Por el contrario, la cepa de Helvella sp. IE1317 mostró mejor crecimiento en las muestras en acículas de pino, previo a la criogenización. En las tres cepas restantes se presentaron condiciones similares de desarrollo micelial en ambos vectores, especialmente para los cultivos de la cepa IE-1316.
Considerando la variabilidad de respuesta observada durante esta etapa del estudio, para la micorrización in vitro se seleccionaron las dos cepas que presentaron disminución del crecimiento micelial en los cultivos recuperados después de la criogenización y que además, mostraron diferencias estadísticas entre los cultivos criogenizados y no criogenizados, en al menos uno de los vectores; esto con el interés de conocer si la técnica de preservación empleada afectaba la capacidad de micorrización del germoplasma.
Cultivo y micorrización de las plántulas
En la Tabla 2 se muestran los porcentajes de germinación, contaminación y ausencia de crecimiento que se obtuvieron con los diferentes tratamientos de desinfección, escarificación y tipos de sustratos de germinación utilizados. En general, se obtuvo un mayor porcentaje de germinación en el tratamiento T1 de desinfección. Por otra parte, en todos los casos, independientemente del tratamiento utilizado, se obtuvo un mayor porcentaje de germinación cuando se utilizó el sustrato a base de tierra, lombricomposta y tepetzil (S), ya que el mayor porcentaje de contaminación se observó en las muestras en las que se utilizó el medio WPM.

En cuanto a la micorrización de las plántulas, no se observó sobrevivencia en los individuos de Pinus montezumae incubados sin micelio, mientras que en las plántulas inoculadas con micelios criogenizados se alcanzó un porcentaje de sobrevivencia de 33% (IE-1317) a 50% (IE-1305), mientras que en los micelios no criogenizados los porcentajes de sobrevivencia fluctuaron entre 33% (IE1317) y 100% (IE-1305). El promedio de altura de los tallos de las plántulas micorrizadas varió entre 0.95 cm (IE-1305 criogenizada) y 1.75 cm (IE-1317 criogenizada). Las variaciones encontradas en la altura de las plántulas no permitieron establecer diferencias estadísticamente significativas (p= 0.05) entre los tratamientos de criogenización (Tabla 3).

En lo que respecta a las observaciones macro y microscópicas, en las plantas inoculadas con Boletus se presentaron estructuras ectomicorrícicas solitarias, de forma monopodial-piramidal, sin ramificar, con extremos rectos, no inflados, cilíndricos, color ocre oscuro y superficie del manto ligeramente lanosa, con rizomorfos redondeados lo que coincide con la descripción de Águeda et al. (2006), pero difiriendo en color; mientras que las estructuras provenientes de las muestras inoculadas con Helvella fueron de color marrón anaranjado a marrón rojizo a más claras en el ápice, lisas, simples y en algunos casos dicotómicas, coincidiendo con la descripción de Arteaga-León et al. (2018); en ambos casos , confirmando la formación del manto fúngico, así como la bifurcación típica de una micorriza en la raíz secundaria (Fig. 4).

Discusión
La recuperación de las cepas de hongos después de la congelación en nitrógeno líquido es un proceso delicado que puede afectar la viabilidad de las muestras. Mata y Pérez Merlo (2003) observaron que, al utilizar semillas de sorgo, la recuperación del micelio se llevaba a cabo a partir del hilio de las semillas, lo que sugería que, de alguna forma, el micelio se mantenía viable dentro de las mismas durante la congelación. Los resultados de este trabajo coinciden con dichas observaciones en el caso de la utilización de las semillas de mijo como vectores. Por otra parte, cuando se utilizaron acículas de pino como vectores, se observó algo similar en cuanto a la protección que brinda la capa externa de esta materia vegetal al micelio, ya que estas estructuras se caracterizan por presentar una epidermis de células muy lignificadas (Caballé et al., 2011), aunado a la presencia de celulosa, hemicelulosa y polifenoles (Sáenz-Esqueda et al., 2010), compuestos que pudieron favorecer y estimular la adecuada recuperación de los diferentes micelios cultivados. Aunque en este trabajo las muestras de cepas de los HEcM solo se mantuvieron en congelación en nitrógeno líquido durante 30 días, los resultados son promisorios y abren la posibilidad de resguardarlas por períodos más largos, ya que se ha mostrado que diversos HEcM pueden ser preservados a través de la criogenización (Obase et al., 2011; Crahay et al., 2017). Sin embargo, será necesario realizar un mayor número de experimentos para corroborar la viabilidad de las cepas en períodos más largos.
En el caso de germinación de las semillas de pino, los porcentajes fueron bajos comparados con los señalados en trabajos de Ardebol-Cantillo et al., (2006) y Gómez Viveros (2013), quienes observaron porcentajes de germinación en WPM de 82% a 76.66%, respectivamente. Así mismo, Gómez Viveros (2013) reporta que la falta de germinación de las semillas se puede atribuir a alguna sustancia utilizada en el proceso de desinfección, lo cual no fue posible determinar en este trabajo, o a una baja viabilidad de la semilla utilizada. La ficha técnica proporcionada por la Conafor especificaba una viabilidad de 80%. Debido a los bajos porcentajes de germinación obtenidos, se implementaron varios tratamientos de desinfección y escarificación de los sustratos con el fin de incrementar la germinación, sin embargo, solo se obtuvo un incremento en el porcentaje de germinación al utilizar suelo estéril como sustrato.
En la inoculación de la plántula usando peat foam como sustrato, el hongo se vio favorecido por las propiedades presentadas por este material, entre las que destacan: retención de humedad, porosidad, fácil manipulación y estabilidad del pH del medio líquido, lo que resulta en un crecimiento más homogéneo del hongo (Gómez Viveros, 2013). En este trabajo, el uso de piezas cilíndricas de peat foam facilitó el manejo de las plántulas, ya que la cavidad interna de estas piezas permitió acomodar el sistema radicular de la plántula junto al implante de micelio, manteniendo este contacto cuando la pieza de peat foam fue introducida en el tubo de ensayo. Este sistema, sencillo pero novedoso, permitió mantener a las plántulas en buenas condiciones y facilitar la obtención y observación de la micorriza. Además, el uso del medio líquido de MNM fue adecuado para el cultivo de las ectomicorrizas in vitro, ya que las cepas presentaron un buen crecimiento micelial, tal como se había observado en trabajos previos (García-Rodríguez et al., 2006; Chávez et al., 2009; Díaz et al., 2009; Gómez Viveros, 2013) por lo que es una buena opción para cultivos in vitro de HEcM.
La preservación de cepas en nitrógeno líquido es un método adecuado para la conservación de organismos como hongos filamentosos y ectomicorrizógenos; sin embargo, existe poca información referente al impacto de la criogenización sobre características importantes como la colonización de la raíz o la capacidad de micorrización. La mayoría de los estudios relacionados con inoculación de cepas de HEcM se han enfocado en la supervivencia del hongo después de ser sometido a temperaturas ultra bajas y rara vez es tomada en cuenta la fase simbiótica del aislamiento (Corbery y Le Tacon, 1997; Kitamoto et al., 2002; Homolka et al., 2007; Crahay, Declerck, et al., 2013; Crahay, Wevers, et al., 2013; Homolka, 2013). Ya que esta etapa del trabajo se enfocó en determinar si las cepas de HEcM criopreservadas perdían su capacidad de formar la relación simbiótica con el hospedero, la revisión de las raíces de las plántulas de Pinus montezumae con estructuras características de la asociación simbiótica de HEcM permitió determinar que las cepas de Boletus aff. edulis y Helvella sp., recuperadas del tratamiento de criogenización y de subcultivo continuo, no perdieron su capacidad de formar micorriza, por lo que los resultados obtenidos en este trabajo coinciden con lo encontrado por Crahay, Wevers, et al. (2013). Además, la colonización de las raíces por micelio criogenizado no mostró ningún efecto negativo sobre el crecimiento y desarrollo de las plántulas. Estos resultados sugieren que las cepas de HEcM se podrían conservar a través de la congelación en nitrógeno líquido y se esperaría que los micelios recuperados tuviesen la capacidad de formar micorrizas y ayudar al desarrollo de las plántulas.
Las experiencias de micorrización entre Pinus montezumae y Boletus edulis han sido positivas cuando la fuente de inoculación proviene de basidiomas deshidratados y molidos (Martínez-Reyes et al., 2012). Recientemente, Sehgal y Sagar (2022) lograron observar la micorrización in vitro de B. edulis en Pinus gerardiana, en un sustrato estéril preparado con vermiculita y turba e inoculado con los cultivos fúngicos. En este sentido, lograr la inoculación con cepas criogenizadas es un gran avance en las investigaciones enfocadas a los hongos micorrícicos comestibles, pues provee de una nueva técnica para tal fin. En este trabajo las plántulas de Pinus montezumae fueron cultivadas en condiciones de esterilidad in vitro, lo que permite inferir que las micorrizas formadas muy probablemente son de las especies de hongos inoculadas. Las micorrizas de B. edulis encontradas en este trabajo difieren, en el color, de las descritas por Águeda et al. (2006), sin embargo, coinciden en la coloración ocre oscura observada por Mello (2012) y Sehgal y Sagar (2022).
A diferencia de otras regiones del mundo, la inoculación con hongos del grupo Ascomycota ha sido escasamente estudiada en México. Un trabajo que aporta información sobre este tema es el de Martínez-Amores et al. (1990), quienes estudiaron la efectividad de la formación de ectomicorrizas aplicando soluciones de esporas de varios hongos, entre ellos Helvella lacunosa con Pinus patula y Pinus radiata. En este sentido, la formación de ectomicorrizas con Helvella sp. in vitro es un paso importante para la posibilidad de aplicar una técnica alternativa, ya que usualmente ha sido utilizada la inoculación con solución de esporas. Sin embargo, es en el grupo de los ascomicetos en donde se tienen avances muy significativos a través del cultivo de las trufas (Tuber melanosporum) y otras especies del género Tuber (Martínez de Aragón et al., 2012). Se tiene registro del manejo de las plantas micorrizadas desde 1790 al descubrir que, si se trasplantaban las plántulas que se encontraban creciendo bajo un árbol que ya producía trufas, eventualmente ellas también producirían trufas (Zambonelli et al., 2015). Este sencillo descubrimiento sentó la base para la que hoy es un negocio que produce millones de dólares, ya que una sola trufa de 50 g puede llegar a valer 1320 euros (Tartufo, 2022).
Conclusiones
Si bien la investigación con los hongos micorrizógenos tiene avances considerables, aún está lejos el contar con sistemas controlados para el cultivo, conservación y manejo de estos hongos a escala de campo. Los resultados obtenidos en este trabajo muestran la factibilidad de utilizar la criogenización de micelios, técnica empleada para hongos saprobios, como un proceso viable para la conservación de germoplasma de HEcM, lo que posibilita mantener las cepas por largos periodos bajo condiciones estables que reducen los riesgos de presentar modificaciones de sus capacidades fisiológicas, en comparación con otras técnicas menos confiables, como es la resiembra continua en medios de cultivo.
En la parte de micorrización in vitro, se destaca el potencial de aplicar un método novedoso utilizando materiales de bajo costo enfocados a realizar inoculaciones controladas que permitan obtener gran cantidad de plántulas para apoyar la recuperación de áreas boscosas. Aunque aún falta mucho por hacer, las técnicas desarrolladas en esta contribución aportan elementos para la micorrización de especies arbóreas que permitan un cierto equilibrio entre la conservación de la importante biodiversidad fúngica existente en los bosques nacionales y las actividades socioeconómicas de recolección, consumo y venta de especies comestibles silvestres realizadas por sus pobladores.
Reconocimientos
Gerardo Mata y Dulce Salmones agradecen a las autoridades del Instituto de Ecología, A. C., las facilidades técnicas y el soporte financiero otorgado para realizar sus investigaciones. A Melanie Brewster Salmones se le agradecen los dibujos que ilustran la figura 1.
Referencias
Águeda, B., Parladé, J., de Miguel, A. M., & Martínez-Peña, F. (2006). Characterization and identification of field ectomycorrhizae of Boletus edulis and Cistus Ladanifer. Mycologia, 98(1), 23-30. https://doi.org/10.1080/15572536.2006.11832709
Ardebol-Cantillo, R., Rodriguez de Francisco, L., Rosales, Y., & Alvarado O., G. (2006). Germinación in vitro de Pinus cubensis Griseb. Ciencias Holguín, 12(3), 1-12.
Arteaga-León, C., Pérez-Moreno, J., Espinosa-Victoria, D., Almaraz-Suárez, J. J., Silva-Rojas, H., & Delgado-Alvarado, A. (2018). Ectomycorrhizal inoculation with edible fungi increases plant growth and nutrient contents of Pinus ayacahuite. Revista Mexicana de Biodiversidad, 89(4), 1089-1099. https://doi.org/10.22201/ib.20078706e.2018.4.2235
Baeza-Guzmán, Y., Medel-Ortiz, R., & Garibay-Orijel, R. (2017). Caracterización morfológica y genética de los hongos ectomicorrízicos asociados a bosques de Pinus hartwegii en el Parque Nacional Cofre de Perote, Veracruz. Revista Mexicana de Biodiversidad, 88(1), 41-48. https://doi.org/10.1016/j.rmb.2017.01.027
Brundrett, M., Bougher, N., Dell, B., Grove, T., & Malajczuk, N. (1996). Working with mycorrhizas in forestry and agriculture. Monograph 32. Australian Center for International Agricultural Research.
Burrola-Aguilar, C., Garibay-Orijel, R., & Hernández-Tellez, M. (2012). Los hongos comestibles silvestres del estado de México: propuesta para su aprovechamiento. En J. E. Sánchez V., & G. Mata (Eds.), Hongos comestibles y medicinales en Iberoamérica: Investigación y desarrollo en un entorno multicultural (pp. 39-49). El Colegio de la Frontera Sur-Instituto de Ecología, A.C.
Caballé, G., Reising, C., & Cohen, L. (2011). Valor nutritivo y disponibilidad de materia seca de pino ponderosa en sistemas silvopastoriles. Ciencia & Investigación Forestal, 17(1), 63-76. https://doi.org/10.52904/0718-4646.2011.359
Camargo-Ricalde, S. L., Montaño, N. M., de la Rosa-Mera, C. J., & Montaño Arias, S. A. (2012). Micorrizas: Una gran unión debajo del suelo. Revista Digital Universitaria, 13(7), 1-19.
Carrasco-Hernández, V., Pérez-Moreno, J., Espinosa-Hernández, V., Almaraz-Súarez, J. J., Quintero-Lizaola, R., & TorresAquino, M. (2011). Contenido de nutrientes e inoculación con hongos ectomicorrízicos comestibles en dos pinos neotropicales. Revista Chilena de Historia Natural, 84(1), 83-96. https://dx.doi.org/10.4067/S0716-078X2011000100006
Chávez, M. D., Pereira, C. G., & Machuca, H. C. (2009). Efecto de tipos de inóculos de tres especies fúngicas en la micorrización controlada de plántulas de Pinus radiata. Bosque (Valdivia), 30(1), 4-9. http://dx.doi.org/10.4067/S0717-92002009000100002
Corbery, Y., & Le Tacon, F. (1997). Storage of ectomycorrhizal fungi by freezing. Annals of Forest Science, 54(2), 211-217. https://doi.org/10.1051/forest:19970208
Crahay, C., Declerck, S., Colpaert, J. V., Pigeon, M., & Munaut, F. (2013). Viability of ectomycorrhizal fungi following cryopreservation. Fungal Biology, 117(2), 103-111. https://doi.org/10.1016/j.funbio.2012.12.003
Crahay, C., Wevers, J., Munaut, F., Colpaert, J. V., & Declerck, S. (2013). Cryopreservation of ectomycorrhizal fungi has minor effects on root colonization of Pinus sylvestris plantlets and their subsequent nutrient uptake capacity. Mycorrhiza, 23(6), 463-471. https:/doi.org/10.1007/s00572-013-0489-8
Crahay, C., Munaut, F., Colpaert, J. V., Huret, S., & Declerck, S. (2017). Genetic stability of ectomycorrhizal fungi is not affected by cryopreservation at −130 °C or cold storage with repeated subcultivations over a period of 2 years. Mycorrhiza , 27(6), 595-601. https:/doi.org/10.1007/s00572-017-0770-3
Díaz, G., Flores, R., & Honrubia, M. (2009). Descripción de cultivos miceliares de Boletales neotropicales y europeos (Boletus grupo edulis, Boletellus y Suillus) y formación de primordios de B. edulis en cultivo puro. Revista Mexicana de Micología, 30, 1-7. http://www.scielo.org.mx/pdf/rmm/v30/v30a1.pdf
Endo, N., Kawamura, F., Kitahara, R., Sakuma, D., Fukuda, M., & Yamada, A. (2014). Synthesis of Japanese Boletus edulis ectomycorrhizae with Japanese red pine. Mycoscience, 55(5), 405416. https://doi.org/10.1016/j.myc.2013.11.008
García-Rodríguez, J. L., Pérez-Moreno, J., Aldrete, A., CetinaAlcalá, V. M., & Vaquera-Huerta, H. (2006). Caracterización del hongo silvestre ectomicorrízico Pisolithus tinctorius (Pers.) Coker et Couch en cultivo y en simbiosis con eucalipto y pino. Agrociencia, 40(5), 665-676. https://agrocienciacolpos.org/index.php/agrociencia/article/view/498/498
Garibay-Orijel, R., Morales-Marañon, E., Domínguez-Gutiérrez, M., & Flores-García, A. (2013). Caracterización morfológica y genética de las ectomicorrizas formadas entre Pinus montezumae y los hongos presentes en los bancos de esporas en la Faja Volcánica Transmexicana. Revista Mexicana de Biodiversidad, 84(1), 153-169. https://doi.org/10.7550/rmb.29839
Garibay-Orijel, R., & Ruan-Soto, F. (2014). Listado de los hongos silvestres consumidos como alimento tradicional en México. En A. Moreno Fuentes, & R. Garibay Orijel (Eds.), La etnomicología en México: Estado del arte. (pp. 91-109). Red de Etnoecología y Patrimonio Biocultural (CONACYT)-Universidad Autónoma del Estado de Hidalgo-Instituto de Biología (UNAM)-Sociedad Mexicana de Micología-Asociación Etnobiológica Mexicana, A.C.-Grupo Interdisciplinario para el Desarrollo de la Micología en México-Sociedad Latinoamericana de Etnobiología.
Gómez Viveros, F., (2013). Inoculación in vitro de ectomicorrizas comestibles asociados con Pinus pseudostrobus Lindl. y Pinus patula Schiede ex Schltdl. & Cham [Tesis de licenciatura, Universidad Veracruzana].
Hawksworth, D. L. (2004). Fungal diversity and its implications for genetic resource. Studies in Micology, 50, 9-18. https://www.studiesinmycology.org/sim/Sim50/002Fungal_diversity_and_its_implications_for_genetic_resource_collections.pdf
Hernández-Santiago, F., Martínez-Reyes, M., Pérez-Moreno, J., CarreraMartínez, A., & García-Rodríguez, J. L. (2021). Aislamiento de cepas de hongos ectomicorrízicos y producción de inóculo forestal. En G. Mata, & D. Salmones (Eds.), Técnicas de aislamiento, cultivo y conservación de cepas de hongos en el laboratorio (pp. 87-99). Instituto de Ecología, A.C.
Homolka, L. (2013). Methods of cryopreservation in fungi. En V. K. Gupta, M. G. Tuohy, M. Ayyachamy, K. M. Turner, & A. O’Donovan (Eds.), Laboratory protocols in fungal biology: Current methods in fungal biology (pp. 9-16). Springer-Verlag. http://link.springer.com/chapter/10.1007/978-1-4614-2356-0_2
Homolka, L., Lisá, L., Kubátová, A., Váñová, M., Janderová, B., & Nerud, F. (2007). Cryopreservation of filamentous micromycetes and yeasts using perlite. Folia Microbiologica, 52(2), 153-157. https:/doi.org/10.1007/BF02932154
Islam, F., & Ohga, S. (2013). Effects of media formulation on the growth and morphology of ectomycorrhizae and their association with host plant. ISRN Agronomy, 2013, 317903. https://dx.doi.org/10.1155/2013/317903
Kitamoto, Y., Susuki, A., Shimada, S., & Yumanaka, K. (2002). A new method for the preservation of fungus stock cultures by deep-freezing. Mycoscience , 43(2), 143-149. https:/doi.org/10.1007/s102670200021
Lalaymia, I., Cranenbrouck, S., & Declerck, S. (2014). Maintenance and preservation of ectomycorrhizal and arbuscular mycorrhizal fungi. Mycorrhiza, 24(5), 323-337. https:/doi.org/10.1007/s00572-013-0541-8
Largent, D., Johnson, D., & Watling, R. (1977). How to identify mushrooms to genus III: Microscopic features. Mad River Press Incorporate, Eureka.
Linde, G. A., Luciani, A., Lopes, A. D., Silveira do Valle, J., & Barros Colauto, N. (2018). Long-term cryopreservation of basidiomycetes. Brazilian Journal of Microbiology, 49(2), 220-231. https://doi.org/10.1016/j.bjm.2017.08.004
López Santiago, N. L. (2013). Cultivo y caracterización in vitro de cepas de hongos ectomicorrízicos procedentes de Cofre de Perote, Veracruz [Tesis de licenciatura, Universidad Veracruzana].
Marx, D. H. (1969). The influence of ectotropic mycorrizhal fungi on the resistance of pine roots to pathogenic infections. II: Production, identification, and biological activity of antibiotics produced by Leucapaxillus cerealis var. piceina. Phytopathology, 59(4), 411-417.
Martínez-Amores, E., Valdéz, M., & Quintos, M. (1990). Seedling growth and ectomycorrhizal colonization of Pinus patula and P. radiata inoculated with spores of Helvella lacunosa, Russula brevipes or Lycoperdon perlatum. New Forests, 4(4), 237-245. https:/doi.org/10.1007/BF00119203
Martínez de Aragón, J., Fischer, C., Bonet, J. A., Olvera, A., Oliach, D., & Colinas, C. (2012). Economically profitable post fire restoration with black truffle (Tuber melanosporum) producing plantations. New Forests , 43(5), 615-630. https:/doi.org/10.1007/s11056-012-9316x
Martínez-Reyes, M., Pérez-Moreno, J., Villarreal-Ruiz, L., FerreraCerrato, R., Xoconostle-Cázares, B., Vargas-Hernández, J., & Honrubia-García, M. (2012). Crecimiento y contenido nutrimental de Pinus greggii Engelm. inoculado con el hongo comestible ectomicorrízico Hebeloma mesophaeum (Pers.) Quél. Revista Chapingo Serie Ciencias Forestales y del Ambiente, 18(2), 183-192. https://doi.org/10.5154/r.rchscfa.2010.11.112
Mata, G., & Pérez Merlo, R. (2003). Spawn viability in edible mushrooms after freezing in liquid nitrogen without a cryoprotectant. Criobiology, 47(1), 14-20. https://doi.org/10.1016/S0011-2240(03)00064-6
Mata, G., & Salmones, D. (2005). Preservation of shiitake spawn stocks by cryogenic storage. En MushWorld (Ed.), Shiitake cultivation, Mushroom growers´ handbook 2. (pp. 42-45). MushWorld.
Mata, M. (1999). Macrohongos de Costa Rica (Vol. 1). INBio.
Mata, M., Halling, R., & Mueller, G. M. (2003). Macrohongos de Costa Rica (Vol. 2). INBio.
Mello, A. (2012). State of the art of the research on Boletus edulis. En A. Zambonelli, & G. M. Bonito (Eds.), Edible ectomycorhrizal mushrooms: current knowledge and future prospects (pp. 73-81). Springer. https:/doi.org/10.1007/978-3-642-33823-6_5
Miller, O. K., & Miller, H. H. (2006). North American mushrooms. A field guide to edible and inedible fungi. Falcon Guide.
Obase, K., Lee, S. Y., Chun, K. W., & Lee, J. K. (2011). Regeneration of ectomycorrhizal fungal isolates following deep freezer storage. Mycobiology, 39(2), 133-136. https:/doi.org/10.4489/MYCO.2011.39.2.133
Organización de las Naciones Unidas para la Alimentación y la Agricultura [FAO] (2020). El estado de los bosques del mundo. FAO. https://www.fao.org/3/ca8642es/online/ca8642es.html
Pérez-Moreno, J., Lorenzana-Fernández, A., Medel Ortiz, R., Ferrera Cerrato, R., & Mata, G. (2019). Los hongos ectomicorrízicos de México: una perspectiva global. En F. J. Álvarez Sánchez, P. Rodríguez Guzmán, & A. Alarcón (Eds.), Biodiversidad de microrganismos de México: importancia, aplicación y conservación (pp. 135169). Universidad Nacional Autónoma de México.
Pérez-Moreno, J., Martínez-Reyes, M., Hernández-Santiago, F., & OrtizLópez, I. (2020). Climate change, biotechnology, and Mexican neotropical edible ectomycorrhizal mushrooms. En J. PérezMoreno, A. Guerin-Laguette, R. Flores Arzú, & F. Q. Yu (Eds.), Mushrooms, humans and nature in a changing world perspective from ecological, agricultural and social sciences (pp. 61-100). Springer. https:/doi.org/10.1002/ppp3.10199
Pérez-Moreno, J., Mortimer, P. E., Xu, J., Karunarathna, S. C., & Li, H. (2021). Global perspectives on the ecological, cultural, and socioeconomic relevance of wild edible fungi. Studies in Fungi, 6(1), 408-424. https:/doi.org/10.5943/sif/6/1/31
Pérez Ochoa, D. A. (2014). Capacidad micorrízica de cepas criogenizadas de Boletus edulis y Helvella sp. in vitro [Tesis de licenciatura, Universidad Veracruzana].
Ramírez Miguel, A. A., Hernández Díaz, A. F., Valenzuela Encinas, C., Garibay-Orijel, R., & Truong, C. (2021). Hongos ectomicorrízicos asociados a plantas jóvenes de Pinus patula y Quercus crassifolia en plantaciones del sistema matarrasa de la Sierra Juárez de Oaxaca, México. Scientia Fungorum, 51, e1289. https:/doi.org/10.33885/sf.2021.51.1289
Rasband, W. S. (2009). Image J. U. S. National Institutes of Health. https://imagej.nih.gov/ij/
Repác, I. (2011). Ectomycorrhizal inoculum and inoculation techniques. En M. Rai, & A. Varma (Eds.), Diversity and biotechnology of ectomycorrhizae (pp. 43-63). Springer. https:/doi.org/10.1007/978-3-642-15196-5_3
Sáenz-Esqueda, M. A., Rosales-Castro, M., Rocha-Guzmán, N. E., Gallegos-Infante, J. A., & González-Laredo, R. F. (2010). Contenido fenólico y acción antioxidante de extractos de acículas de Pinus cooperi, P. durangensis, P. engelmanii y P. teocote. Madera y Bosques, 16(3), 37-48. https://doi.org/10.21829/myb.2010.1631165
Sehgal, A. K., & Sagar, A. (2022) In vitro mycorrhization of two wild edible Bolete species with Pinus gerardiana - an economically high altitude conifer. Biosciences Biotechnology Research Asia, 19(4), 1009-1018. http://dx.doi.org/10.13005/bbra/3050
StatSoft (2008). Statistica Versión 8 for Windows. StatSoft, Inc.
Tartufo. (2022). Truffle price updated on 7 March 2022. Tartufo. https://www.tartufo.com/en/truffle-prices/
Zambonelli, A., Iotti, M., & Hall, I. (2015). Current status of truffle cultivation: recent results and future perspectives. Micologia Italiana, 44(1), 31-40. http://dx.doi.org/10.6092/issn.2465-311X/5593
Zong, K., Huang, J., Nara, K., Chen, Y., Shen, Z., & Lian, C. (2015). Inoculation of ectomycorrhizal fungi contributes to the survival of tree seedlings in a copper mine tailing. Journal of Forest Research, 20(6), 493-500. https:/doi.org/10.1007/s10310-015-0506-1
Notas de autor
*Autora de correspondencia. dulce.salmones@inecol.mx